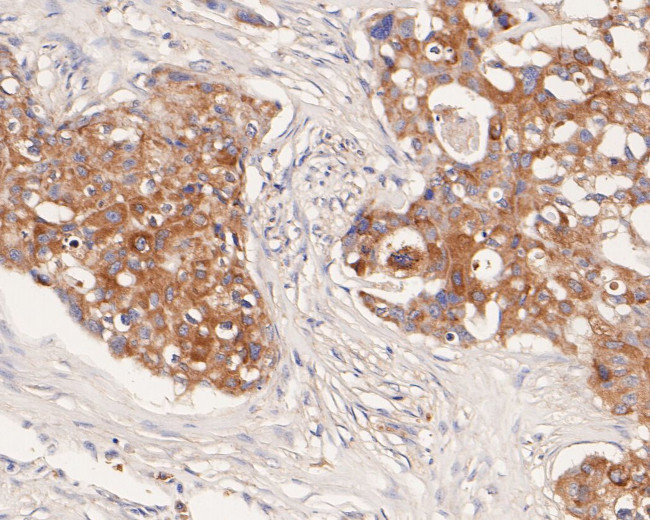
CX3CL1 Antibody in Immunohistochemistry (Paraffin) (IHC (P))

Search
Huabio
CX3CL1 Polyclonal Antibody
{{$productOrderCtrl.translations['antibody.pdp.commerceCard.promotion.promotions']}}
{{$productOrderCtrl.translations['antibody.pdp.commerceCard.promotion.viewpromo']}}
{{$productOrderCtrl.translations['antibody.pdp.commerceCard.promotion.promocode']}}: {{promo.promoCode}} {{promo.promoTitle}} {{promo.promoDescription}}. {{$productOrderCtrl.translations['antibody.pdp.commerceCard.promotion.learnmore']}}
图: 1 / 3
CX3CL1 Antibody (HA500304) in IHC (P)



产品信息
HA500304
种属反应
宿主/亚型
分类
类型
抗原
偶联物
形式
浓度
规格
纯化类型
保存液
内含物
保存条件
运输条件
靶标信息
Chemokines are a family of proteins associated with the trafficking of leukocytes in immune surveillance and inflammatory cell recruitment. They are classified based on the positions of key cysteine residues. CX3CL1 is a CX3C chemokine known to induce adhesion and migration of leukocytes mediated by a membrane-bound and soluble form respectively. Recent experiments have shown that CX3CL1 can suppress the production of nitrous oxide, interleukin-6, and TNF-a in activated microglia and neuronal cells, suggesting that it may act as an intrinsic inhibitor against neurotoxicity by activated microglia. Its receptor, CX3CR1, also functions as a co-receptor for HIV-1 and HIV-2 envelope fusion and virus infection, which can be inhibited by CX3CL1.
仅用于科研。不用于诊断过程。未经明确授权不得转售。
篇参考文献 (0)
生物信息学
蛋白别名: C-X3-C motif chemokine 1; chemokine (C-X3-C motif) ligand 1; CX3C membrane-anchored chemokine; CX3CL1; Fractalkine; Neurotactin; small inducible cytokine subfamily D (Cys-X3-Cys), member 1 (fractalkine, neurotactin); small inducible cytokine subfamily D (Cys-X3-Cys), member-1; Small-inducible cytokine D1; unnamed protein product
基因别名: A-152E5.2; ABCD-3; C3Xkine; CX3CL1; CXC3; CXC3C; FKN; fractalkine; neurotactin; NTN; NTT; SCYD1
UniProt ID: (Human) P78423
Entrez Gene ID: (Human) 6376